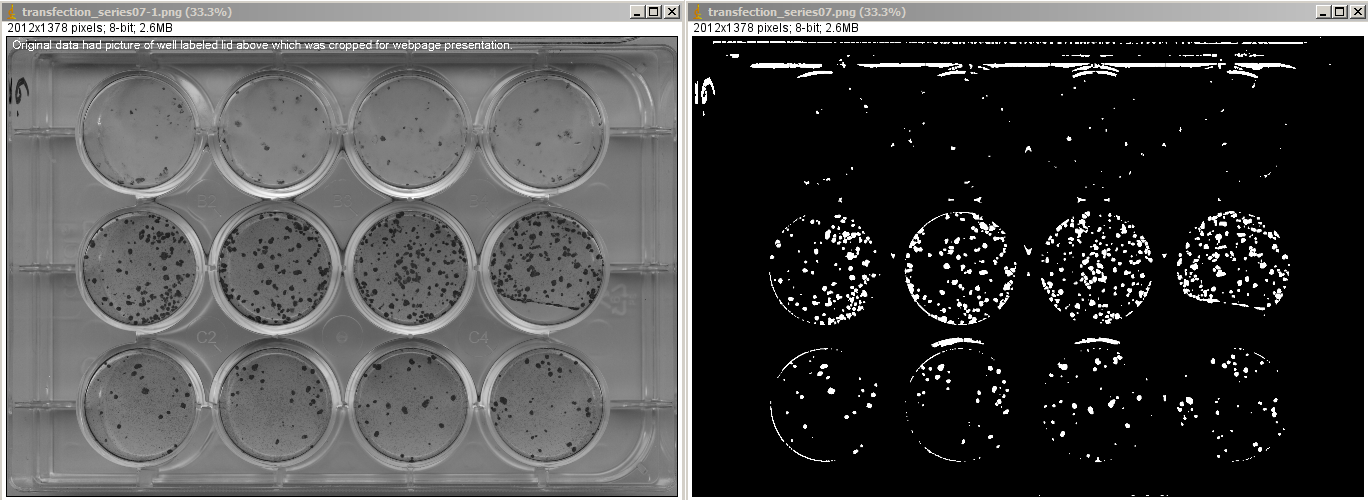

Counting monochrome spots is perhaps the simplest function people ask for and there are many tutorials and programs that can do this.
However, it is deceptively complicated. The spots have to be segmented by the computer.
The most common problems I encounter with user data:
Here is an example of a simple solution for a simple problem that worked well:

If the well plate were always exactly perpendicular to the image edge, then it would be easy to automate multiwell plate measurements. More errors could have been eliminated by filtering based on shape. But we found that for repeats across many plates, this gave consistent meaninful results.
Details: If you try the macro on the data presented here and it doesn't work, it's because 1.) the autothresholding requires the original 16 bits and the top half of the image that was cropped off here for web presentation. When you develop a method for a particular set of pictures, you need to test it with your own thresholding method.